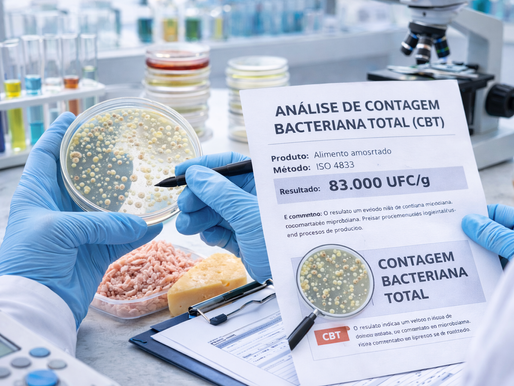
Monitore a qualidade microbiológica dos seus produtos e processos com análises confiáveis e reconhecidas.

top of page
Buscar


Custos e Benefícios das Análises Laboratoriais Antes do Lançamento de Produtos
Entenda os custos e benefícios das análises laboratoriais antes do lançamento de produtos e como esses ensaios reduzem riscos, garantem conformidade e fortalecem a qualidade industrial.
6 de jan.7 min de leitura

Contagem Bacteriana Total (CBT): o que indica e por que monitorar
A contagem bacteriana total (CBT) é um importante indicador da qualidade microbiológica de alimentos, água e ambientes. Entenda o que indica e por que monitorar.
27 de nov. de 20255 min de leitura
bottom of page
